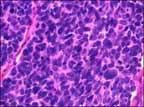
Small Cells

Get
a Free
Info Packet

FOR MORE INFORMATION
please call
1-800-400-1805
We will gladly answer your questions and send you a free packet with additional
information on:
- New treatment options
- New clinical trials
- Doctors
- Hazardous jobs and products
- Veteran's Resources
- Financial Assistance
Small Cell Lung Cancer
is less common than non-small cell lung cancer. Small Cell Lung Cancer accounts for fifteen percent of all diagnoses, and is most prevalent among smokers. Small Cell Lung Cancer is also called oat cell cancer, because malignant cells are oat-shaped. Small Cell Lung Cancer is aggressive, and spreads quickly. In approximately seventy percent of cases, the cancer has spread to other organs by the time the disease is diagnosed. Once metastasized, a Small Cell Lung Cancer patient is not a candidate for surgery, but does respond to chemotherapy.
Limited Small Cell Lung Cancer
About one-third of patients with SCLC have limited disease at initial diagnosis. This stage is highly responsive to a combination of systemic chemotherapy and radiation. Substantial shrinkage of tumor occurs in as many as 80 to 90% of patients with this treatment. Complete clinical remission can be achieved in 50 to 60% of all patients with this stage of disease. Recent trials of chemotherapy and radiation show median survival times of 15 to 18 months, 2-year survival rates of 30 to 40%, and 5-year survival rates of 10 to 15%.
Extensive Small Cell Lung Cancer
In the two-thirds of patients with SCLC with extensive disease at initial diagnosis, the response rate to systemic chemotherapy is 60 to 80%, median survival time is 9 to 10 months, and the 2-year survival rate is less than 10%. Five-year survival with extensive disease is rarely reported. Complete clinical remission is achieved in only 20% to 30%. The chemotherapeutic agents given for extensive disease are identical to those used for limited disease.
Notice that the cells are almost only blue nucleus (DNA) material making them "small" under the microscope.
Notice that the cells are almost only blue nucleus (DNA) material making them "small" under the microscope.

Free Mesothelioma Information
- New Treatment Options
- Clinical Trials
- Best Doctors
- Veteran's Resources
- Financial Assistance
1-800-400-1805


